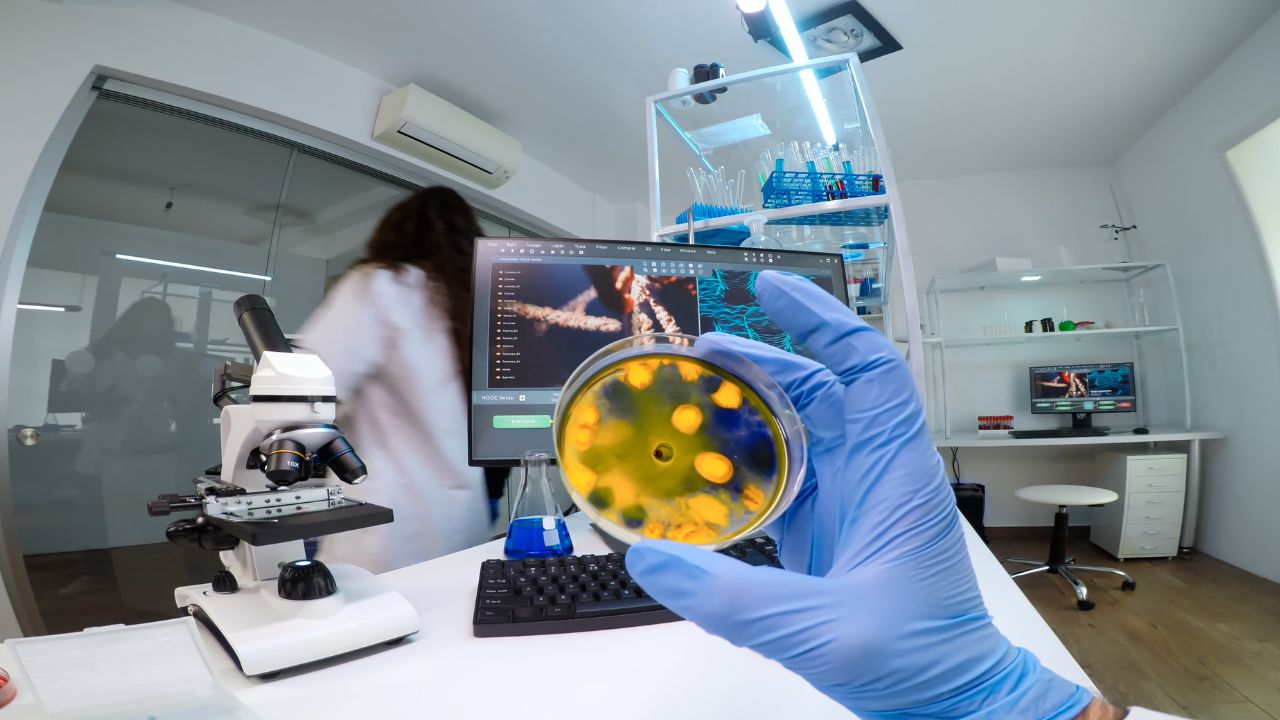
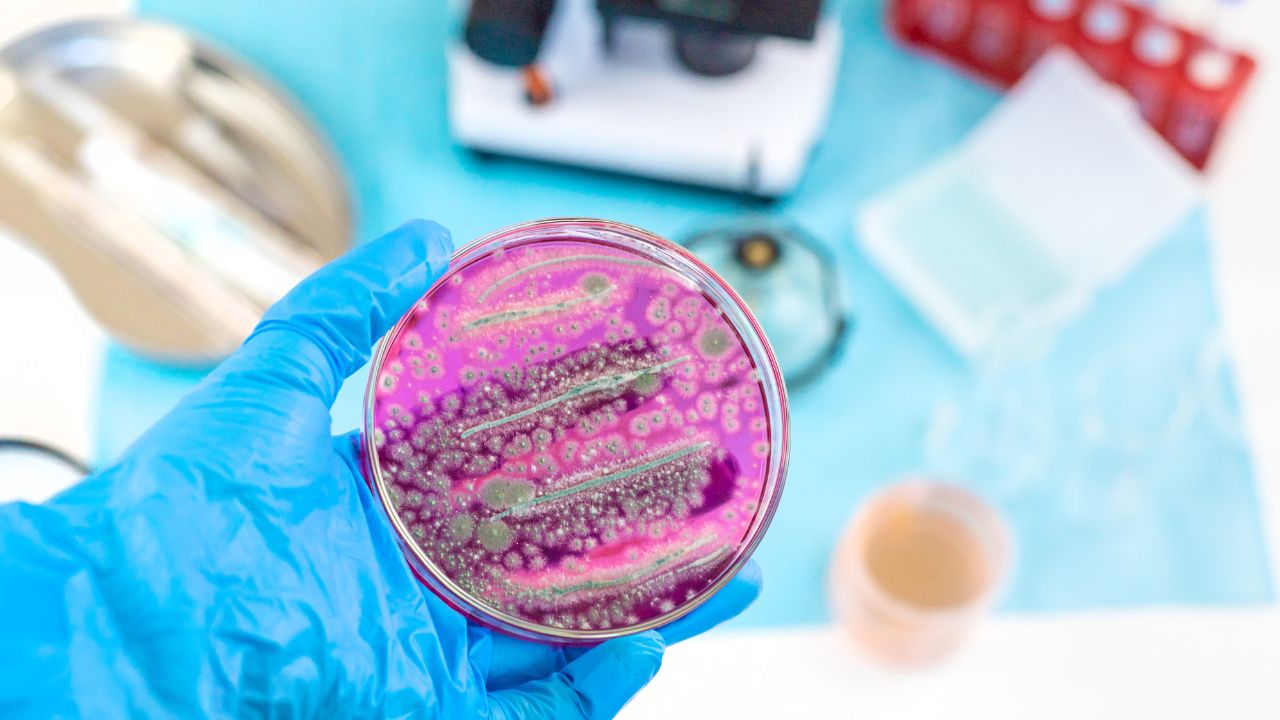
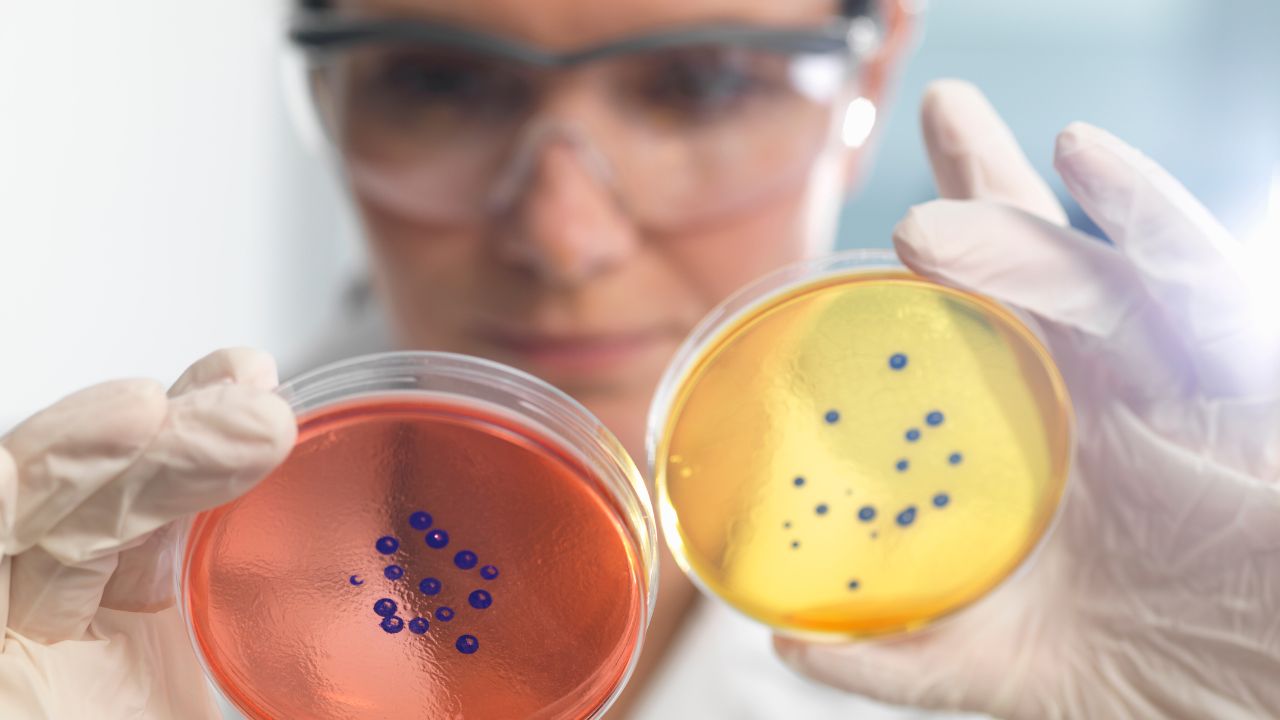

A microbiologia é um campo científico que estuda os microorganismos, incluindo bactérias, vírus, fungos e protozoários.
Apesar de muitos microrganismos serem invisíveis a olho nu, seu impacto na saúde humana, na produção de alimentos, na indústria farmacêutica, na biotecnologia e no meio ambiente é imenso.
Este artigo explora a importância da microbiologia e como essa disciplina desempenha um papel crucial em diversas esferas da vida cotidiana:
A microbiologia na saúde pública
A microbiologia, pela Análises Clínicas e Microbiologia, desempenha um papel crucial na saúde pública, sendo uma das disciplinas fundamentais para a identificação, prevenção e controle de doenças infecciosas. O trabalho dos microbiologistas é vital para a proteção da saúde da população e para a manutenção de um ambiente seguro e saudável. A seguir, são apresentados os principais aspectos da contribuição da microbiologia para a saúde pública:
1. Identificação de patógenos: os microbiologistas são especialistas em detectar e caracterizar agentes infecciosos, como bactérias, vírus e fungos, em amostras biológicas obtidas de pacientes. Técnicas laboratoriais avançadas permitem identificar a presença desses patógenos, possibilitando diagnósticos rápidos e precisos. A detecção precoce de agentes infecciosos é fundamental, pois, sem esses testes, muitas infecções podem passar despercebidas, aumentando o risco de surtos e epidemias. Um diagnóstico apropriado não apenas orienta o tratamento, mas também ajuda a identificar fontes de infecção e a prevenir sua disseminação.
2. Desenvolvimento de vacinas e medicamentos: a microbiologia é essencial no desenho e na produção de vacinas, que são ferramentas cruciais para a prevenção de doenças. O conhecimento profundo sobre a biologia e o comportamento dos patógenos, como o HIV, a influenza e outros vírus, é fundamental para desenvolver vacinas eficazes que induzam uma resposta imunológica robusta. Além disso, a microbiologia contribui significativamente para a descoberta e o desenvolvimento de novos medicamentos. A identificação de alvos terapêuticos e a pesquisa de propriedades antimicrobianas em microrganismos são processos que resultam em novas opções de tratamento.
3. Controle de infecções: os microbiologistas desempenham um papel ativo em estratégias de controle de infecções, tanto em ambientes hospitalares quanto em comunidades. Eles colaboram na implementação de práticas de higiene, esterilização e segurança alimentar que são essenciais para evitar a propagação de doenças. Protocolos de controle de infecções, como a vigilância regular de equipamentos e superfícies, ajudam a minimizar riscos e proteger pacientes e profissionais de saúde. Além disso, durante surtos de doenças infecciosas, a atuação dos microbiologistas é crucial para descrever a natureza dos patógenos envolvidos e implementar medidas de contenção.
4. Vigilância epidemiológica: a microbiologia é a base da vigilância epidemiológica, que monitora a ocorrência e a propagação de doenças infecciosas. Essa vigilância permite rastrear surtos, identificar padrões de infecção e compreender as dinâmicas de transmissão de patógenos nas comunidades. Os dados gerados por essa vigilância são fundamentais para influenciar políticas de saúde pública e direcionar ações de prevenção e controle. Por meio de análises estatísticas e epidemiológicas, os microbiologistas podem fornecer informações críticas que ajudam a alocar recursos adequadamente e implementar intervenções eficazes.
Em resumo, a microbiologia na saúde pública é um campo de extrema importância que abrange desde a identificação de patógenos até o desenvolvimento de vacinas e a implementação de medidas de controle de infecções.
O trabalho dos microbiologistas não apenas salva vidas, mas também promove a saúde coletiva, ajudando a construir um ambiente seguro e saudável para toda a comunidade. Com os constantes desafios que surgem, como novas pandemias e o aumento da resistência a antimicrobianos, a importância da microbiologia somente tende a crescer.
Portanto, fortalecer essa área de conhecimento é vital para garantir um futuro mais saudável e resiliente.
Microbiologia e indústria alimentícia
Na indústria alimentícia, a microbiologia é um componente essencial que garante a segurança, qualidade e inovação dos produtos alimentares. Sua aplicação abrangente e diversificada torna possível não apenas a proteção da saúde pública, mas também a criação de alimentos saborosos e nutritivos.
A seguir, exploramos as principais contribuições da microbiologia neste setor vital:
1. Segurança alimentar: a segurança alimentar é uma prioridade máxima na indústria de alimentos, e os microbiologistas desempenham um papel fundamental na proteção dos consumidores. Eles realizam análises rigorosas para identificar patógenos potencialmente perigosos, como Salmonella, Escherichia coli, Listeria monocytogenes e outros microrganismos que podem levar a intoxicações alimentares. A implementação de técnicas microbiológicas, como cultivo em meios seletivos e testes moleculares, permite a detecção precoce de contaminantes nos produtos antes da distribuição. Essas medidas asseguram que os alimentos estejam livres de patógenos e contribuam para a saúde do consumidor, proporcionando confiança na segurança dos produtos que chegam às prateleiras.
2. Fermentação e conservação: a microbiologia é a base de muitos processos de fermentação que são fundamentais para a produção de uma variedade de alimentos. Microrganismos, como bactérias lácticas e leveduras, são empregados em processos de fermentação para transformar açúcares em produtos como iogurte, queijos, pães e bebidas fermentadas. Esses microorganismos não apenas contribuem para o sabor e a textura dos alimentos, mas também podem aumentar a digestibilidade e a biodisponibilidade de nutrientes. Além disso, técnicas de conservação, como a fermentação, ajudam a prolongar a vida útil dos produtos, reduzindo a dependência de conservantes químicos. O uso de microrganismos na conservação de alimentos atende à crescente demanda por opções mais saudáveis e naturais.
3. Desenvolvimento de novos produtos: a pesquisa microbiológica abre portas para inovações na indústria alimentícia, resultando no desenvolvimento de novos produtos alimentares. Microbiologistas trabalham para criar produtos que atendam às exigências do consumidor moderno, que busca alternativas cada vez mais saudáveis e sustentáveis. O uso de microrganismos para produzir aditivos naturais e desenvolver opções livres de ingredientes artificiais está em ascensão. Por exemplo, a fabricação de substitutos de carne à base de microrganismos ou a utilização de fermentos para criar bebidas probióticas refletem essa tendência. Essa inovação não apenas proporciona uma variedade de opções alimentares, mas também está alinhada com as preocupações ambientais e de saúde pública.
A microbiologia é uma área crucial que sustenta a indústria alimentícia, garantindo a segurança, qualidade e inovação nos produtos alimentares. Com sua contribuição significativa para a segurança alimentar, processos de fermentação e desenvolvimento de novos produtos, os microbiologistas desempenham um papel vital na promoção de uma alimentação segura e saudável.
À medida que os desafios globais aumentam e as demandas dos consumidores evoluem, a microbiologia continuará a ser uma força propulsora na criação de soluções inovadoras e sustentáveis que atendam às necessidades da sociedade contemporânea. A intersecção entre microbiologia e indústria alimentícia não apenas melhora a qualidade de vida, mas também promove um futuro mais saudável para todos.
Microbiologia na indústria farmacêutica
A microbiologia desempenha um papel fundamental na indústria farmacêutica, sendo um campo de pesquisa essencial para o desenvolvimento, produção e controle de qualidade de medicamentos. As aplicações dessa disciplina são vastas e impactam diretamente a eficácia e segurança dos tratamentos disponíveis.
A seguir, destacamos as principais contribuições da microbiologia neste setor vital:
1. Produção de antibióticos: a descoberta e produção de antibióticos representam uma das maiores conquistas da microbiologia. Muitos antibióticos, como a penicilina, são derivados de fungos e bactérias que produzem substâncias antibacterianas como parte de suas defesas naturais. Os microbiologistas exploram e isolam esses microorganismos para identificar e extrair compostos com propriedades antimicrobianas. Este processo é fundamental para o desenvolvimento de tratamentos eficazes contra uma variedade de infecções bacterianas. A contínua pesquisa na produção de novos antibióticos é vital, especialmente diante do aumento da resistência bacteriana, que representa um desafio crescente na medicina moderna.
2. Testes de qualidade: o controle de qualidade é uma etapa crítica na indústria farmacêutica, e os profissionais de microbiologia são responsáveis por garantir que os medicamentos sejam seguros e eficazes. Eles realizam testes rigorosos para detectar a presença de contaminantes, como bactérias, fungos e endotoxinas, que podem comprometer a qualidade dos produtos. Esses testes asseguram que os medicamentos atendam aos padrões regulatórios e às expectativas de segurança do consumidor. Sem esses controles, produtos farmacêuticos poderiam resultar em reações adversas graves ou em falhas terapêuticas, colocando a saúde dos pacientes em risco.
3. Avanços em biotecnologia: a microbiologia também impulsiona os avanços em biotecnologia, permitindo a criação de terapias inovadoras e personalizadas. O uso de técnicas microbiológicas, como a engenharia genética, tem levado ao desenvolvimento de vacinas de DNA e terapia gênica, que oferecem novas esperanças no tratamento de doenças crônicas e genéticas. Essas inovações são particularmente promissoras no combate a doenças complexas, como vários tipos de câncer e doenças raras, proporcionando abordagens inovadoras que podem transformar o tratamento e melhorar a qualidade de vida dos pacientes.
Em suma, a microbiologia na indústria farmacêutica é um pilar essencial que abrange desde a produção de antibióticos até o controle de qualidade e os avanços em biotecnologia. O trabalho dos microbiologistas é fundamental na busca por novos tratamentos e na garantia da segurança dos medicamentos, contribuindo para a saúde e bem-estar da população.
À medida que a ciência avança e novos desafios emergem, a microbiologia continuará a desempenhar um papel crucial na inovação e no desenvolvimento de soluções eficazes para os problemas de saúde que enfrentamos. A colaboração entre microbiologia e indústria farmacêutica é, portanto, vital para o futuro da medicina e para a melhoria continuada da saúde global.
Microbiologia e meio ambiente
A microbiologia desempenha um papel fundamental na proteção e preservação do meio ambiente, atuando em diversas áreas que vão desde a recuperação de ambientes contaminados até a promoção da saúde dos ecossistemas. A seguir, exploramos as principais contribuições da microbiologia para a sustentabilidade e o gerenciamento ambiental.
1. Bioremediação: a bioremediação é um dos campos mais importantes da microbiologia ambiental. Esse processo envolve a utilização de microrganismos, como bactérias e fungos, para remover ou neutralizar poluentes em solos e águas contaminadas. Por meio de suas capacidades metabólicas, estes microorganismos podem degradar substâncias tóxicas, como hidrocarbonetos, solventes industriais e pesticidas, convertendo-os em compostos menos prejudiciais ou até mesmo em substâncias benignas. Essa abordagem natural é frequentemente mais sustentável e econômica do que as técnicas tradicionais de descontaminação. A bioremediação é uma ferramenta valiosa na recuperação de áreas afetadas por derramamentos de óleo, resíduos industriais e poluição agrícola, contribuindo significativamente para a restauração e preservação dos habitats naturais.
2. Ciclagem de nutrientes: Os microrganismos são essenciais para a manutenção dos ciclos biogeoquímicos, especialmente os ciclos do carbono e do nitrogênio. Eles desempenham um papel vital na decomposição da matéria orgânica, quebrando resíduos de plantas e animais para liberar nutrientes de volta ao solo. Esse processo não apenas enriquece o solo, mas também garante que as plantas possam acessar os nutrientes necessários para crescimento e desenvolvimento. Além disso, a fixação biológica do nitrogênio, realizada por certas bactérias, converte o nitrogênio atmosférico em formas utilizáveis pelas plantas, favorecendo a fertilidade do solo e a produção agrícola. A saúde dos ecossistemas, a produtividade agrícola e a sustentabilidade dos recursos naturais dependem em grande parte das atividades microbiológicas que facilitam a ciclagem de nutrientes.
3. Mudanças climáticas: A microbiologia também desempenha um papel relevante na compreensão e mitigação das mudanças climáticas. A relação entre microrganismos e gases de efeito estufa, como o metano e o dióxido de carbono, é complexa e deve ser cuidadosamente estudada. Certas bactérias, por exemplo, são responsáveis pela produção de metano em ambientes como pântanos e aterros, e essa emissão pode ser influenciada por fatores ambientais, como temperatura e umidade. Compreender essas dinâmicas é crucial para formular estratégias eficazes de mitigação, visando reduzir as emissões de gases de efeito estufa provenientes de fontes biológicas. Além disso, a microbiologia pode contribuir para soluções sustentáveis, como o desenvolvimento de microrganismos que podem atuar na captura de carbono, ajudando a mitigar as emissões atmosféricas.
Em resumo, a microbiologia é um componente essencial na proteção e preservação do meio ambiente, atuando em três áreas fundamentais: bioremediação, ciclagem de nutrientes e mudanças climáticas. Os microbiologistas desempenham um papel crucial no desenvolvimento de estratégias para a recuperação de ambientes degradados, promovendo a saúde dos ecossistemas e contribuindo para a sustentabilidade dos recursos naturais.
Com os crescentes desafios ambientais enfrentados pelo planeta, a pesquisa e a aplicação do conhecimento microbiológico são mais relevantes do que nunca, contribuindo para um futuro mais sustentável e resiliente. A interação entre microbiologia e meio ambiente é uma chave para a construção de soluções que promovam a harmonia entre os seres humanos e a natureza, assegurando um planeta saudável para as futuras gerações.
A microbiologia no futuro
À medida que o mundo enfrenta desafios globais cada vez mais complexos, como a resistência a antibióticos, pandemias e degradação ambiental, o papel da microbiologia se torna cada vez mais essencial. As inovações e descobertas nessa área não só aprimoram os tratamentos e diagnósticos, mas também abrem novas possibilidades para abordar questões críticas que afetam a saúde e o bem-estar humano. A seguir, exploramos algumas das direções futuras da microbiologia e suas implicações.
1. Inovação em vacinas: uma das áreas mais promissoras da microbiologia é o desenvolvimento de vacinas inovadoras. Avanços recentes em tecnologias, como vacinas de mRNA, mostraram como a microbiologia pode ser crucial para acelerar a resposta a novas infecções. Esse tipo de vacina, que instruí as células do corpo a produzir proteínas específicas do patógeno, demonstrou eficácia rápida e adaptabilidade no combate a vírus, como o SARS-CoV-2, responsável pela COVID-19. Além disso, a pesquisa continua a explorar métodos de vacinação que ativam respostas imunes mais robustas e de longa duração, utilizando microrganismos geneticamente modificados ou novas plataformas de entrega. A capacidade de desenvolver vacinas rapidamente em resposta a surtos emergentes não só salvará vidas, mas também redefinirá as estratégias de saúde pública globais.
2. Soluções sustentáveis: a busca por alternativas sustentáveis na agricultura e na indústria é uma preocupação crescente que demanda novas abordagens microbiológicas. Com as pressões sobre os recursos naturais e as mudanças climáticas, a microbiologia oferece soluções inovadoras para garantir produtividade e segurança alimentar sem comprometer o meio ambiente. Por exemplo, o desenvolvimento de microrganismos que promovem a fertilidade do solo através da fixação biológica do nitrogênio ou que podem degradar poluentes químicos de forma eficiente é essencial para práticas agrícolas sustentáveis. Além disso, a biotecnologia microbiana pode contribuir para a produção de biocombustíveis e compostos químicos a partir de biomassa, diminuindo a dependência de recursos fósseis e contribuindo para a redução das emissões de carbono.
3. Educação e conscientização: à medida que a microbiologia demonstra seu impacto em diversas áreas, a educação sobre microrganismos e suas interações com a saúde e o meio ambiente se torna fundamental. Promover a conscientização pública sobre a importância da microbiologia pode ajudar a combater a desinformação e aumentar o entendimento sobre os benefícios e riscos associados a microorganismos. Programas educacionais que ensinam a população sobre a importância dos microrganismos para a biodiversidade, saúde pública e práticas sustentáveis contribuirão para a formação de cidadãos mais informados e responsáveis. Além disso, a educação em microbiologia pode incentivar a formação de novas gerações de cientistas e profissionais preparados para enfrentar os desafios futuros.
O futuro da microbiologia é promissor e cheio de potencial. À medida que a ciência avança e novas tecnologias emergem, o papel da microbiologia se ampliará na busca por soluções eficazes para os desafios globais que enfrentamos.
Com inovações em vacinas, práticas agrícolas sustentáveis e a educação da população, a microbiologia não só contribuirá para a saúde humana, mas também para a preservação do meio ambiente.
O investimento em pesquisa e no desenvolvimento de soluções microbiológicas é, portanto, essencial para garantir um futuro mais saudável e sustentável para as próximas gerações. A microbiologia, com seu potencial sem limites, se firmará como uma aliada indispensável na construção de um mundo melhor.
A importância da microbiologia é inegável. Desde a saúde pública até a indústria e o meio ambiente, os microorganismos desempenham um papel essencial em muitos dos aspectos mais críticos da vida cotidiana.
Com a contínua evolução da ciência, os microbiologistas se destacam como peças-chave na busca por soluções eficazes para os desafios atuais e futuros da sociedade. Investir em pesquisa e educação nessa área significa investir em um futuro mais saudável, sustentável e seguro para todos.
A microbiologia, portanto, não é apenas uma disciplina científica; é uma ferramenta poderosa para a transformação e melhoria da vida humana em todo o mundo.
Deixe um comentário